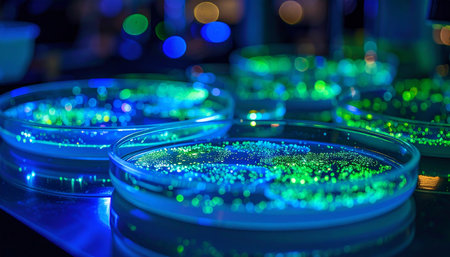
In a darkened laboratory, petri dishes reveal a breakthrough. Genetically modified cells fluoresce with a vibrant green glow under UV light, signaling a successful experiment in biotechnology and a step forward in scientific innovation.の素材

素材 - In a darkened laboratory, petri dishes reveal a breakthrough. Genetically modified cells fluoresce with a vibrant green glow under UV light, signaling a successful experiment in biotechnology and a step forward in scientific innovation.
作品情報
In a darkened laboratory, petri dishes reveal a breakthrough. Genetically modified cells fluoresce with a vibrant green glow under UV light, signaling a successful experiment in biotechnology and a step forward in scientific innovation.
- ID:253591213
- 作品種別:
- 作者名:Selah Maruta
キーワード
類似作品
A sleek black n...
A dishwasher wi...
many empty whit...
A congested sin...
Deluxe colorful...
KEROSENE LAMP -...
black cups are ...
Dirty and clean...
Chopping knives...
Lab bench with ...
Clean dishes li...
A bustling kitc...
Empty plate on ...
white plates an...
Dirty dishes an...
Black plates wi...
A dirty dishes ...
Black plate wit...
Rows of empty p...
A lab workspace...
Cigarette and g...
lots of dirty w...
empty plates on...
Close-up of pet...
A modern labora...
Empty black cer...
Ceramic plates ...
welding wire sp...
Side view of a ...
Elegant black t...
A burnt food on...
Waiter's hand w...
Stack of white ...
A sleek black n...
Minimal kitchen...
Dishes in a res...
A series of emp...
Overfilled kitc...
Lots of dirty d...
Neatly stacked ...
Rows of empty p...
Pile of clean p...
Science lab wit...
Dirty dishes an...
A chef standing...
Explore a capti...
A spacious labo...
White plates an...
Purple ceramic ...